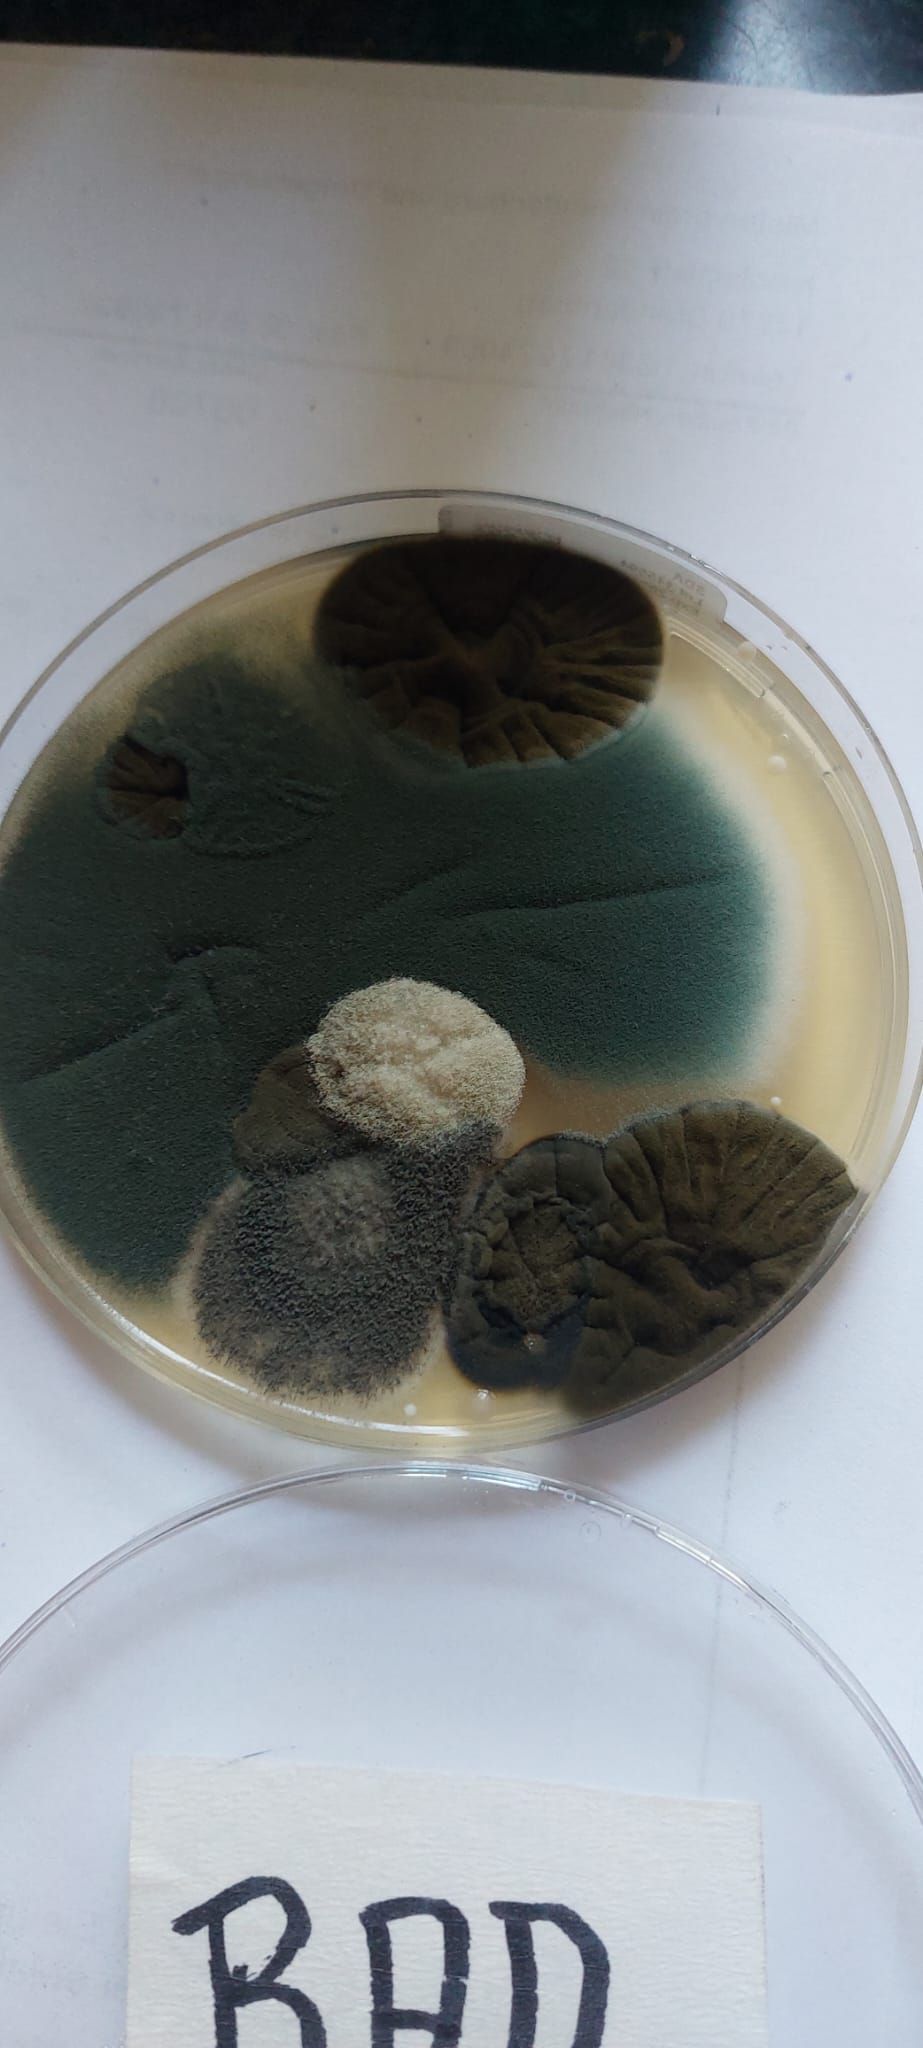

Unsere Dienstleistungen im Überblick:
Gutachtenerstellung
Wir erstellen Privatgutachten. Zum Arbeitsbereich der Privatgutachten gehören diverse Tätigkeitsfelder, die wir für
- Privatpersonen
- Haus- und Wohnungseigentümer
- Wohnungseigentümergemeinschaften
- Hausverwaltungen
- Wohnungsbaugesellschaften, etc.
abdecken.
Diese Tätigkeitsbilder umfassen die:
- Baubegleitung
- Analyse von Schimmelpilzen auf Wänden und sonstigen Oberflächen / Mykologische Diagnostik
- Baubegleitung und Bauleitung von Naturwerksteinobjekten
- Überwachung und Prüfung von Arbeiten an Natursteinen
- Beratung rund ums Thema Haus und Einrichtung / Ideengebung
- Durchführung umfassender Mängelerfassungen, z.B. während der Bauphase oder nach Abschluss von Baumaßnahmen
-Beratende Tätigkeit bei der Durchführung von Bauabnahmen einschließlich Mängelerfassung und Protokollierung sowie Abnahmeempfehlungen
- Bewertung von Bauschäden und Baumängeln
- Durchführung von Beweissicherungen bei Schadensfällen
- Durchführung von Beweissicherungen in Streitfällen
Galerie
Objekte bei denen eine Verkehrswertermittlung durchgeführt wurde
(Reihe von ausgewählten Bilder)
Objekte bei denen eine Baubegleitung durchgeführt wurde
(Reihe von ausgewählten Bilder)
Aus Gründen des Datenschutzes keine vorhanden.
Weitere Bilder befinden sich auf Instagram